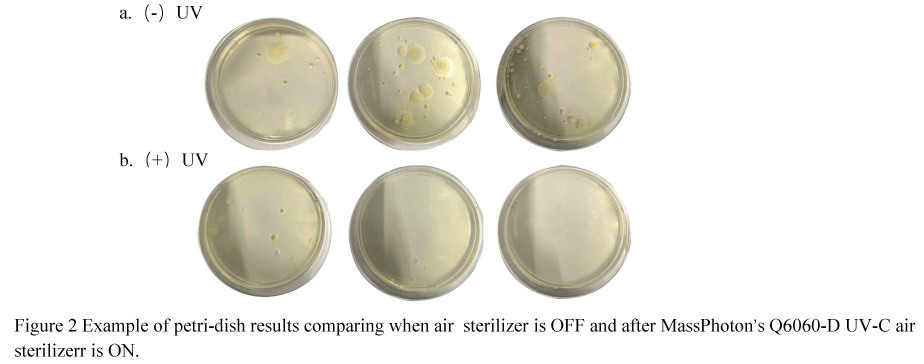
3

Application of UV-C LED Technology in Air sterilizer: Sterilization and Odor Removal
Main text
Figures
Tables
References
Air sterilizers have gained widespread market adoption, but their functionality remains limited to singular purposes such as disinfection or odor removal.The MASSPHOTON ’ s Q6060-D UV-C air sterilizer utilizes solid-state semiconductor technology with UV-C LEDs emitting 260-280nm single-wavelength ultraviolet light, which can inactivate a broad spectrum of microorganisms by blocking DNA and RNA replication. Installed on the ceiling of meeting rooms, garbage rooms, and corridors in a normally operating shopping mall in Hong Kong, the MASSPHOTON ’ s Q6060-D UV-C air sterilizer achieved a sterilization rate of 70.8% in the garbage room and 61.62% in the meeting room. Although during the odor removal test, wall painting activities in a rented shop significantly increased TVOC levels, the use of the MASSPHOTON air sterilizer reduced the initial TVOC level from 10.00 mg/m³ to 3.53 mg/m³ within 2 hours. In a simulated test conducted in a 112 m³ room, after four cigarettes were completely burned, the MASSPHOTON’s Q6060-D UV-C air sterilizer was immediately activated. After 4 hours, the PM2.5 concentration was effectively reduced by 61.1%, and the TVOC concentration was reduced by 98.2%. Using 10% ammonia solution as a volatile ammonia gas test, the ammonia removal rate reached 99.9% within 90 minutes. Based on all experimental results, it can be concluded that the MASSPHOTON ’ s Q6060-D UV-C air sterilizer can effectively reduce the number of natural bacteria in the air while adsorbing particulate matter in the environment, decomposing odor molecules, maintaining air cleanliness and freshness, preventing the spread of respiratory diseases, and protecting vulnerable populations.
Air pollution severely impacts various aspects of our lives, including our living, learning, and working environments. Pollutants such as volatile organic compounds, particulate matter, and pathogens affect the health of the respiratory and nervous systems, while odors from food waste fermentation, toilet smells, and cigarette smoke negatively impact mood. Research by Sierra-Varga et al. found that particles with a diameter of less than 2.5 micrometers (PM2.5) deposit in the alveolar region of the lungs [1]. Pathogens, on the other hand, are suspended in the air in two forms: droplets (diameter >5 μm) and aerosols (diameter ≤5 μm), which can spread diseases through the respiratory system. Aerosol particles, in particular, can survive in enclosed spaces for hours to days and enter the human body through the respiratory system, causing infections [2]. This transmission characteristic has been fully demonstrated during recent epidemics, making air sterilizers a key technological solution for breaking the chain of transmission. Air sterilizers have shown great potential in preventing and reducing airborne diseases [3]. Common air sterilizers on the market primarily use ultraviolet (UV) technology for sterilizer. The use of UV light for sterilizer has a history of several decades [4]. UVC light, with a wavelength of 100-280 nm, inactivates a broad spectrum of microorganisms, including viruses, bacteria, protozoa, fungi, yeast, and algae, by forming pyrimidine dimers—photoproducts of genetic material—that block DNA and RNA replication [5, 6]. However, traditional UV irradiation technology uses a wavelength of 254 nm, which has drawbacks such as the use of toxic mercury, large device size, and ozone production [7]. In contrast, UV-C LEDs emitting at 275 nm are smaller in size, offer higher optical output, eliminate the risk of mercury pollution [8], and have a longer lifespan, up to 25,000 hours, which is 2 to 25 times longer than that of 254 nm mercury vapor lamps [9, 10]. This study focuses on the sterilizer efficacy of air sterilizers using UV-C LED technology for indoor air purification, while also monitoring the removal of specific odors that affect human health, well-being, and comfort. The research fully demonstrates the significant potential of UV-C LED technology in controlling and preventing airborne infections, while addressing the gap in air freshness improvement for such devices.

The sampling method and calculation formula refer to Appendix D of GB28235 - "Hygienic requirements for ultraviolet appliance of disinfection" for sampling. This method is issued by the State Administration for Market Regulation and the Standardization Administration of the People's Republic of China, serving as the national standard of the People's Republic of China, and is more professional and scientific.
3.1 Sterilization rate
A MASSPHOTON's Q6060-D UV-C air sterilizer was installed on the ceiling of a basement level 1 meeting room in a Hong Kong shopping mall to test its natural bacteria elimination rate. The meeting room is used from Monday to Friday, 8:30 am to 11:30 am, by mall office employees. To establish a control group, the airborne bacterial colony count was measured after three days of non-operation. The experimental group data was collected after three consecutive days of operation. Sampling was conducted both before and after meetings to compare the sterilizer effectiveness of the device during continuous room usage. The results showed an average elimination rate of 59.5% before the morning meeting (8:30 am) and 63.7% after continuous use throughout the morning (11:30 am). This indicates an average elimination rate of 61.6% during meeting hours with the device in continuous operation (as shown in Table 1).

As shown in figure 2, depicting the culture medium, clearly shows a significant reduction in natural airborne bacteria after MASSPHOTON’s Q6060-D UV-C air sterilizer turn on. This demonstrates the device's effectiveness in reducing the risk of disease transmission in crowded environments.
Table 2 sterilizer rate Garbage room.



3.3 Testing for Ammonia in Cigarette
In a closed room with a volume of 112 m³ within the factory premises, a MASSPHOTON air sterilizer machine was installed on the ceiling to test its effectiveness in removing PM2.5, formaldehyde, and TVOC after burning 4 cigarettes, as well as its ability to remove ammonia after evaporating 20 ml of 10% ammonia solution for 30 minutes.
Four cigarettes were simultaneously lit inside the room. After they completely burned out, the initial concentrations of PM2.5, formaldehyde, and TVOC were measured using a handheld formaldehyde concentration detector, with values of 3.6 µg/m³, 0.12 ppm, and 0.15 mg/m³, respectively. The air sterilizer machine was then turned on and operated continuously for 4 hours. After this period, the concentrations were measured again, showing that PM2.5 had decreased to 14 µg/m³, formaldehyde to 0.01 ppm, and TVOC to 0.01 mg/m³. The removal rates were 61.10% for PM2.5, 87.50% for formaldehyde, and 98.20% for TVOC, effectively reducing the levels of harmful gases and particulate matter in the enclosed space (as shown in Table 3).
Table 3 Removal of Cigarette Odor by MASSPHOTON’s Q6060-D UV-C air sterilizer Machine.

Using ammonia gas to simulate the odor in a restroom, 20 ml of 10% ammonia solution was placed into two Φ90 × 18 mm petri dishes. The dishes were left uncovered to allow natural evaporation for 30 minutes, and the initial concentration of NH₃ was measured using a portable NH₃ gas detector as the control group. The air sterilizer machine was then turned on, and the indoor ammonia concentration was tested every 10 minutes. After running the air sterilizer machine for 90 minutes, the ammonia concentration decreased from 4.5 ppm to 0.2 ppm, resulting in an ammonia removal rate of 95.5% (as shown in Table 4).
Table 4 Ammonia Removal by MASSPHOTON’s Q6060-D UV-C air sterilizerr

The MASSPHOTON’s Q6060-D UV-C air sterilizer utilizes solid-state semiconductor technology [11] to emit UV-C LED light with a single wavelength of 260-280 nm. Preliminary experiments have shown that this wavelength range does not produce ozone, nor does it result in ultraviolet light leakage [12]. This technology is more environmentally friendly, has a longer lifespan, and consumes less energy [7, 13]. Building on the foundation of maintaining a high sterilizer rate for natural bacteria, the 2.0 version adds a photocatalytic module and a High-Efficiency Particulate Air (HEPA) filter. When exposed to visible light or ultraviolet light [13], the photocatalytic module activates a photocatalytic reaction on the surface of TiO2, generating reactive oxygen species (ROS) such as hydroxyl radicals (OH-) and superoxide radicals (O2-) [13]. These ROS possess strong oxidizing capabilities and can decompose organic compounds, thereby effectively removing and breaking down odorous substances [12]. The HEPA filter is composed of extremely fine interwoven fibers with very small gaps between them, enabling it to effectively capture tiny particulate pollutants in the air. This helps remove fine particulate matter, improve indoor air quality [14], and prevent the spread of diseases.
The MASSPHOTON’s Q6060-D UV-C air sterilizer features mercury-free, ozone-free, and ultraviolet leakage-free operation, along with compact and intelligent design. It allows for human-machine coexistence, efficiently eliminates odors, and includes an IoT module that enables real-time monitoring of indoor air quality via a mobile app. It is an excellent assistant for improving quality of life in environments such as homes, shopping malls, and offices. In the future, further validation of the MASSPHOTON’s Q6060-D UV-C air sterilizer's efficacy in specialized environments such as hospitals can be explored.
[1] Sierra-Vargas, M.P. and L.M. Teran, Air pollution: impact and prevention. Respirology: official journal of the Asian Pacific Society of Respirology, 2012. 17(7): p. 1031-1038.
[2] Rabaan AA, A.S.A.M., Airborne transmission of SARS-CoV-2Airborne transmission of SARS-CoV-2 is the dominant route of transmission:droplets and aerosols. Infez Med, 2021. 29(1):10-19.
[3] Lu Song, J.Z.C.W., Airborne pathogenic microorganisms and air cleaning technology development: A review. 2022, Journal of Hazardous Materials,: Journal of Hazardous Materials.
[4] NG, R., The history of ultraviolet germicidal irradiation for air sterilizer. Public health reports, 2010. 125(1): p. 15-27.
[5] Bintsis T, L.E.R.R., Existing and potential applications of ultraviolet light in the food industry- a critical review. 2000.
[6] Yaun BR, S.S.E.J., Marcy JE. Inhibition of pathogens on fresh produce by ultraviolet energy. 2004.
[7] Glaab J, L.N.C.H., Skin tolerant inactivation of multiresistant pathogens using far-UVC LEDs. 2021.
[8] Singh D., S.A.R.V., Assessment of SARS-CoV-2 surrogate inactivation on surfaces and in air using UV and blue light-based intervention technologies.. 2023.
[9] Gerchman, Y., et al., UV-LED sterilizer of Coronavirus: Wavelength effect. Journal of Photochemistry and Photobiology, B. Biology: Official Journal of the European Society for Photobiology, 2020. 212{Issue}:: p. 112044-1-112044-7.
[10] Kohs J, L.T.G.C., Studies on the Virucidal Effects of UV-C of 233 nm and 275 nm Wavelengths.. 2024.
[11] MacIsaac, S.A., et al., Im p roved sterilizer pe rformance for 280 nm LEDs over 254 nm low-p ressure UV lam ps in communit y wastewater. Scientific Re p orts, 2023. 13(1).
[12] Shafa Muhammad, F.M.A.E., Stud y of UV-C LED Technolo gy on In-door Air sterilizer: An Effective Mercur y -free and Ozone-free Method to Irradicate Airborne Microor g anisms. 2024, Association for Com p utin g Machiner y , New York, NY, USA.
[13] Foster, H.A., et al., Photocatal y tic sterilizer usin g titanium dioxide: S p ectrum and mechanism of antimicrobial activit y . A pp lied Microbiolo gy and Biotechnolo gy , 2011. 90(6): p . 1847-1868.
[14] Chen CF, H.C.C.Y., Efficac y of HEPA Air Cleaner on Im p rovin g Indoor Particulate Matter 2.5 Concentration. 2022.








Get in Touch
Recent Posts
-
 MASSPHOTON will participate in WATERTECH CHINA 2026 (June 9–11, Shanghai), showcasing advanced UVC LED water disinfection modules for residential, commercial, and industrial applications. With 5-log (99.999%) disinfection performance, mercury-free operation, and high integration flexibility, the solutions support sustainable and smart water treatment. Visitors are invited to explore innovations at Booth 2.1H-413.
MASSPHOTON will participate in WATERTECH CHINA 2026 (June 9–11, Shanghai), showcasing advanced UVC LED water disinfection modules for residential, commercial, and industrial applications. With 5-log (99.999%) disinfection performance, mercury-free operation, and high integration flexibility, the solutions support sustainable and smart water treatment. Visitors are invited to explore innovations at Booth 2.1H-413. -
 This study examines how temperature influences UV-C LED performance and water disinfection efficiency. Higher temperatures reduce output power, accelerate degradation, and lead to insufficient disinfection dose. Effective thermal management is essential to ensure stable performance and reliable sterilization.
This study examines how temperature influences UV-C LED performance and water disinfection efficiency. Higher temperatures reduce output power, accelerate degradation, and lead to insufficient disinfection dose. Effective thermal management is essential to ensure stable performance and reliable sterilization.








